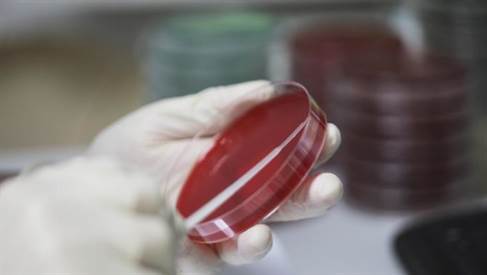
teste analize

Institutul Național de Sănătate Publică a anunțat noile norme de testare pentru coronavirus, precum și regulile de internare și externare a pacienților cu Covid-19. Recomandările sunt făcute pe baza sfaturilor oferite de Centrul European de Control al Bolilor (ECDC).
INSP precizează că Romania se află în prezent în stadiu pre-epidemic, cu cazuri de import și cazuri de transmitere locală restrânsă, fără să existe dovezi de transmitere intracomunitară susținută.
În aceste condiții, strategia de testare trebuie sa fie axată pe detectarea rapidă a cazurilor de Covid-19, pentru a limita transmiterea, și pe obținerea de dovezi de transmitere comunitară nedetectaăa.
Prin urmare, vor avea prioritate la testare persoanele simptomatice care au fost în străinătate, contacți apropiați simptomatici ai cazurilor confirmate, personal medico-sanitar (inclusiv asimptomatic) contact apropiat cu caz confirmatm, cazuri de infecție respiratorie acută severă, care au fost testate negativ pentru gripă, din toate categoriile de varstă și din toate spitalele și persoane instituționalizate simptomatice.
Testarea se face doar la recomandarea medicului, atât în sistemul public, cât și în cel privat de sănătate.